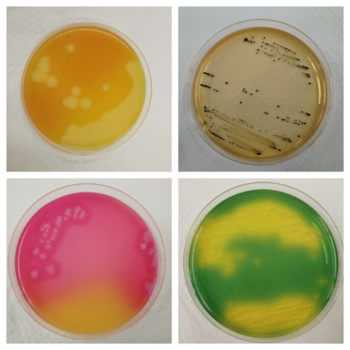
4つの食中毒細菌の培地の写真

食中毒等の検査
衛生検査課では市民の健康の安全確保を目的とし、保健所が主体となり実施する行政検査(食品検査、食中毒検査、感染症検査、家庭用品等の検査)と、市民からの依頼により実施する依頼検査(水質検査)を実施しています。このページでは、食中毒検査について紹介します。
保健所は、食中毒が疑われる場合、喫食者や原因と疑われる食品関係施設の調査や検査を実施し、科学的・総合的に食中毒であるか否かを判断します。衛生検査課では、原因物質、原因食品を特定するための検査を行っています。食中毒の原因物質には、細菌、ウイルス、寄生虫、化学物質、自然毒などがあります。
食中毒をおこす細菌の検査
(左下)セレウス菌(右下)病原性大腸菌のコロニーの様子
黄色ブドウ球菌、赤痢菌、サルモネラ属菌、腸管出血性大腸菌O157等の病原性大腸菌、カンピロバクター、セレウス菌、ウェルシュ菌、腸炎ビブリオなどを検査しています。上記は各細菌が培地上で発育したときの様子です。
食中毒をおこすウイルスの検査

ノロウイルス、ロタウイルス、サポウイルス等のウイルスの遺伝子をリアルタイムPCR装置を使用して検査しています。
食中毒をおこす寄生虫等の検査

(右)アニサキス虫体を光学顕微鏡で観察した様子
アニサキス、クドア・セプテンプンクタータ、サルコシスティス・フェアリーを検査しています。
この情報はお役に立ちましたか?
お寄せいただいた評価はサイト運営の参考といたします。
このページに関するお問い合わせ
保健医療部 衛生検査課 検査担当
〒350-1104 川越市小ケ谷817番地1
電話番号:049-227-5104 ファクス番号:049-224-2261
保健医療部 衛生検査課 検査担当 へのお問い合わせは専用フォームをご利用ください。








